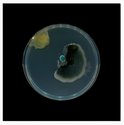
Dane Mitchell, Archive of Dust (British Museum, Room 18, no.2), 2001-ongoing (collected 2023, cultured 2024, printed 2025), Giclee print, aluminium. 800 mm x 800 mm
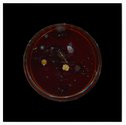
Dane Mitchell, Archive of Dust (British Museum, Room 18, no.6), 2001-ongoing (collected 2023, cultured 2024, printed 2025), Giclee print, aluminium. 800 mm x 800 mm
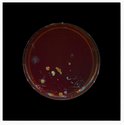
Dane Mitchell, Archive of Dust (British Museum, Room 18, no.8), 2001-ongoing (collected 2023, cultured 2024, printed 2025), Giclee print, aluminium. 800 mm x 800 mm

John Hurrell – 10 December, 2025
The result is a show of curiously unusual conceptual abstractions. Little blobby compositional dramas enclosed in circular dishes; some pink, others blue. The coloration is sweet but dark, with a hint of aerial photography very high up over a vaguely beanlike city. They look like broken egg yolks in a pan—with some frozen mixed vegetables chucked in—organic shaped emulsions suspended in a granular sea, unstable viscous fluids turbulently coagulating perhaps in anticipation of scientific inspection.
So here is a peculiar question.
What kind of bodily experience in the Two Rooms gallery can we expect from an artist who usually delights in downplaying the experiential, emphasizing the mental over the bodily? What sort of spatial encounter awaits within the normal conventional art-ordained & sanctified architecture—where now, with Mitchell anyway, sculptural materiality is instead overtly diminished? At least within a ‘normal’ viewer-life-size scale.
Despite that, the interesting thing is that these large photographs are oddly quite painterly and can be enjoyed through that sensual ‘lens’. You can be openly cranky and ignore (if you wish to be deliciously ‘irresponsible’) the provided lengthy discussions that elaborate on their materiality, referenced imperialist politics and museological / scientific connotations.
These enlargements are big, bold, ‘beautiful’ and accessible. The twelve photographs are of bacterial colonies cultivated in dust that has come from Room 18 of the British Museum, the same room that exhibits the stolen Parthenon Marbles. Dust that originally coated them was collected for Mitchell in 2023, bacteria was cultivated from it in Petri dishes in 2024, and the results photographically documented over 2025.
The result is a show of curiously unusual conceptual abstractions. Little blobby compositional dramas enclosed in circular dishes; some pink, others blue. The coloration is sweet but dark, with a hint of aerial photography very high up over a vaguely beanlike city that is highly fragmented. They (sort-of) look like broken egg yolks in a pan—with some frozen mixed vegetables chucked in—organic shaped emulsions suspended in a granular sea, unstable viscous fluids turbulently coagulating perhaps in anticipation of scientific inspection.
John Hurrell

Two Rooms presents a program of residencies and projects
Two Rooms presents a program of residencies and projects Advertising in this column
Advertising in this column



This Discussion has 0 comments.
Comment
Participate
Register to Participate.
Sign in
Sign in to an existing account.